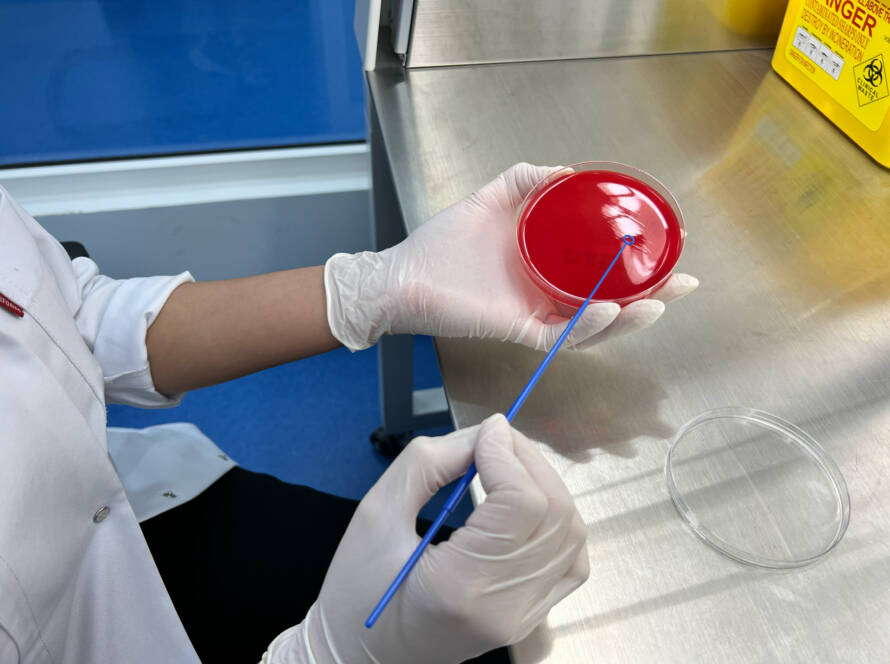

Dicta sunt explicabo. Nemo enim ipsam voluptatem quia voluptas sit aspernatur aut odit aut fugit, sed quia.
Dicta sunt explicabo. Nemo enim ipsam voluptatem quia voluptas sit aspernatur aut odit aut fugit, sed quia.
Mauris eu nisi eget nisi imperdiet vestibulum. Nunc sodales vehicula risus. Suspendisse id mauris sodales, blandit tortor eu, sodales justo. Morbi tincidunt, ante vel suscipit volutpat, turpis enim volutpSectetur adipiscing…
Mauris eu nisi eget nisi imperdiet vestibulum. Nunc sodales vehicula risus. Suspendisse id mauris sodales, blandit tortor eu, sodales justo. Morbi tincidunt, ante vel suscipit volutpat, turpis enim volutpSectetur adipiscing…
Mauris eu nisi eget nisi imperdiet vestibulum. Nunc sodales vehicula risus. Suspendisse id mauris sodales, blandit tortor eu, sodales justo. Morbi tincidunt, ante vel suscipit volutpat, turpis enim volutpSectetur adipiscing…
Mauris eu nisi eget nisi imperdiet vestibulum. Nunc sodales vehicula risus. Suspendisse id mauris sodales, blandit tortor eu, sodales justo. Morbi tincidunt, ante vel suscipit volutpat, turpis enim volutpSectetur adipiscing…
Mauris eu nisi eget nisi imperdiet vestibulum. Nunc sodales vehicula risus. Suspendisse id mauris sodales, blandit tortor eu, sodales justo. Morbi tincidunt, ante vel suscipit volutpat, turpis enim volutpSectetur adipiscing…
Mauris eu nisi eget nisi imperdiet vestibulum. Nunc sodales vehicula risus. Suspendisse id mauris sodales, blandit tortor eu, sodales justo. Morbi tincidunt, ante vel suscipit volutpat, turpis enim volutpSectetur…
Mauris eu nisi eget nisi imperdiet vestibulum. Nunc sodales vehicula risus. Suspendisse id mauris sodales, blandit tortor eu, sodales justo. Morbi tincidunt, ante vel suscipit volutpat, turpis enim volutpSectetur adipiscing…
Mauris eu nisi eget nisi imperdiet vestibulum. Nunc sodales vehicula risus. Suspendisse id mauris sodales, blandit tortor eu, sodales justo. Morbi tincidunt, ante vel suscipit volutpat, turpis enim volutpSectetur…